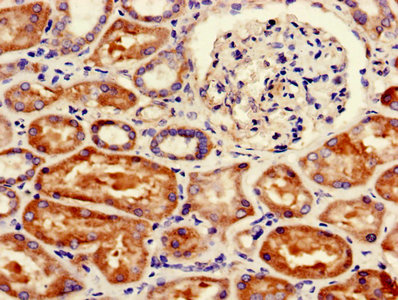

-
中文名稱:FANCC兔多克隆抗體
-
貨號:CSB-PA008415LA01HU
-
規格:¥440
-
圖片:
-
Western Blot
Positive WB detected in: Jurkat whole cell lysate, NIH/3T3 whole cell lysate
All lanes: FANCC antibody at 3µg/ml
Secondary
Goat polyclonal to rabbit IgG at 1/50000 dilution
Predicted band size: 64 kDa
Observed band size: 64 kDa -
Immunohistochemistry of paraffin-embedded human kidney tissue using CSB-PA008415LA01HU at dilution of 1:100
-
Immunofluorescent analysis of MCF-7 cells using CSB-PA008415LA01HU at dilution of 1:100 and Alexa Fluor 488-congugated AffiniPure Goat Anti-Rabbit IgG(H+L)
-
-
其他:
產品詳情
-
產品名稱:Rabbit anti-Homo sapiens (Human) FANCC Polyclonal antibody
-
Uniprot No.:
-
基因名:FANCC
-
別名:bA80I15.1 antibody; FA 3 antibody; FA3 antibody; FAC antibody; FACC antibody; FANCC antibody; FANCC_HUMAN antibody; Fanconi anemia complementation group C antibody; Fanconi anemia complementation group C protein antibody; Fanconi anemia group C protein antibody; Fanconi pancytopenia type 3 antibody; FLJ14675 antibody; Protein FACC antibody
-
宿主:Rabbit
-
反應種屬:Human, Mouse
-
免疫原:Recombinant Human Fanconi anemia group C protein (1-210AA)
-
免疫原種屬:Homo sapiens (Human)
-
標記方式:Non-conjugated
本頁面中的產品,FANCC Antibody (CSB-PA008415LA01HU),的標記方式是Non-conjugated。對于FANCC Antibody,我們還提供其他標記。見下表:
-
克隆類型:Polyclonal
-
抗體亞型:IgG
-
純化方式:>95%, Protein G purified
-
濃度:It differs from different batches. Please contact us to confirm it.
-
保存緩沖液:Preservative: 0.03% Proclin 300
Constituents: 50% Glycerol, 0.01M PBS, PH 7.4 -
產品提供形式:Liquid
-
應用范圍:ELISA, WB, IHC, IF
-
推薦稀釋比:
Application Recommended Dilution WB 1:500-1:5000 IHC 1:20-1:200 IF 1:50-1:200 -
Protocols:
-
儲存條件:Upon receipt, store at -20°C or -80°C. Avoid repeated freeze.
-
貨期:Basically, we can dispatch the products out in 1-3 working days after receiving your orders. Delivery time maybe differs from different purchasing way or location, please kindly consult your local distributors for specific delivery time.
-
用途:For Research Use Only. Not for use in diagnostic or therapeutic procedures.
相關產品
靶點詳情
-
功能:DNA repair protein that may operate in a postreplication repair or a cell cycle checkpoint function. May be implicated in interstrand DNA cross-link repair and in the maintenance of normal chromosome stability. Upon IFNG induction, may facilitate STAT1 activation by recruiting STAT1 to IFNGR1.
-
基因功能參考文獻:
- mutation IVS4+4A>T is the most prevalent mutation in our group of patients. This analysis of Pakistani patients also suggests that there is no significant difference between IVS4+4A>T homozygotes and the rest of the patients with regard to severity of clinical phenotype. PMID: 28425259
- The finding that FANCC overexpression reduced betacell apoptosis advances the potential for an alternative approach to the treatment of Diabetes mellitus caused by FANCC defects PMID: 29901137
- Lung adenocarcinomas in both male and female patients were associated with (a) genotypic polymorphisms of FANCC and FANCD1. PMID: 26842001
- Israeli ATM, BLM, and FANCC heterozygous mutation carriers are not at an increased risk for developing cancer. PMID: 26778106
- FANCC interacts and co-localizes with STMN1 at centrosomes during mitosis. We also showed that FANCC is required for STMN1 phosphorylation. PMID: 26466335
- FANCC interferes with UNC5A's functions in apoptosis and suggest that FANCC may participate in developmental processes through association with the dependence receptor UNC5A. PMID: 24676280
- The successful in vitro repair of the mutated Fanconi anemia FANCC gene using the CRISPR/Cas9 system has been described. PMID: 25545896
- deregulations of the FANCC-mediated DNA damage repair pathway and the PTCH1-associated sonic hedgehog pathway are associated with the development of early dysplastic head and neck lesions. PMID: 21861228
- we identified faults in two genes, Fanconi C and Bloom helicase( FANCC and BLM), in six families. Faults in these genes appear to increase the risk of developing breast cancer PMID: 23028338
- FANCC polymorphisms might be associated with the obstructive symptoms in allergic diseases. PMID: 21670957
- FA DNA repair genes, FANCD2, FANCL, and FANCC, are transcriptionally upregulated differently in melanoma compared with non-melanoma skin cancer PMID: 21697891
- genetic diversity in FANCA, FANCC and FANCL does not support an association of these genes with cervical cancer susceptibility in the Swedish population. PMID: 21543111
- Correct mRNA processing at a mutant TT splice donor in FANCC ameliorates the clinical phenotype in Fanconi anemia patients and is enhanced by delivery of suppressor U1 snRNAs. PMID: 20869034
- we identified a hepatocellular carcinoma cell line harboring an inactivating mutation of the FANCC gene, specifically causing proximal FA pathway inactivation and the classic cellular DNA interstrand-crosslinking agents-hypersensitivity phenotype PMID: 20509860
- study found genetic interaction between Fanconi anemia(FA)gene FANCC and Ku70; results indicate FA pathway promotes homologous recombination repair of DNA double-strand breaks (DSBs) by counteracting Ku70; suggest this achieved by modification of DSBs PMID: 20538911
- The Fanconi anemia protein, FANCE, promotes the nuclear accumulation of this protein. PMID: 12239156
- Hsp70 requires the cooperation of FANCC to suppress PKR activity and support survival of hematopoietic cells and FANCC does not require the multimeric Fanconi anemia complex to exert this function PMID: 12397061
- Fancc-/- phenotypically defined cell populations enriched for hematopoietic stem and progenitor cells exhibit increased cycling PMID: 12763929
- FANCC undergoes proteolytic modification by a caspase into a predominant 47-kDa ubiquitinated protein fragment. Lack of proteolytic modification at the putative cleavage site delays apoptosis. PMID: 14625294
- Fanconi anemia C gene product regulates expression of genes involved in differentiation and inflammation. PMID: 15077170
- Inappropriate activation of Protein kinase regulated by RNA may cause mutations in FANCC> PMID: 15299030
- Data show that the Fanconi anemia protein FANCC cooperate with key mutagenesis and repair processes that enable replication of damaged DNA. PMID: 15327776
- spontaneous SCE levels were elevated approximately 2-fold in cells deficient in Fanconi anemia gene FANCC PMID: 15616572
- FANCC, FANCE, and FANCD2 form a ternary complex in the Fanconi anemia DNA damage response pathway PMID: 16127171
- analysis of two new mutations that inactivate the function of the FANCC protein PMID: 16429406
- nuclear accumulation of FANCE does not rely solely on its nuclear localization signal motifs, but also on FANCC PMID: 16513431
- FANCC-deficient cells are hypersensitive to DNA cross-linking reagents. PMID: 17490643
- We found six differentially expressed proteins; among them, the checkpoint mediator protein MDC1 whose expression was disrupted in FANCC-/- cells. PMID: 17977515
- the first report to describe hypermethylation of FANCL in leukemia PMID: 18607065
- Differential association of alterations in FANCC and PTCH1 with that of PHF2, XPA and two breast cancer susceptibility genes (BRCA1/BRCA2) in the two age groups suggests differences in their molecular pathogenesis. PMID: 18990233
顯示更多
收起更多
-
相關疾病:Fanconi anemia complementation group C (FANCC)
-
亞細胞定位:Nucleus. Cytoplasm. Note=The major form is nuclear. The minor form is cytoplasmic.
-
組織特異性:Ubiquitous.
-
數據庫鏈接:
Most popular with customers
-
-
YWHAB Recombinant Monoclonal Antibody
Applications: ELISA, WB, IHC, IF, FC
Species Reactivity: Human, Mouse, Rat
-
Phospho-YAP1 (S127) Recombinant Monoclonal Antibody
Applications: ELISA, WB, IHC
Species Reactivity: Human
-
-
-
-
-